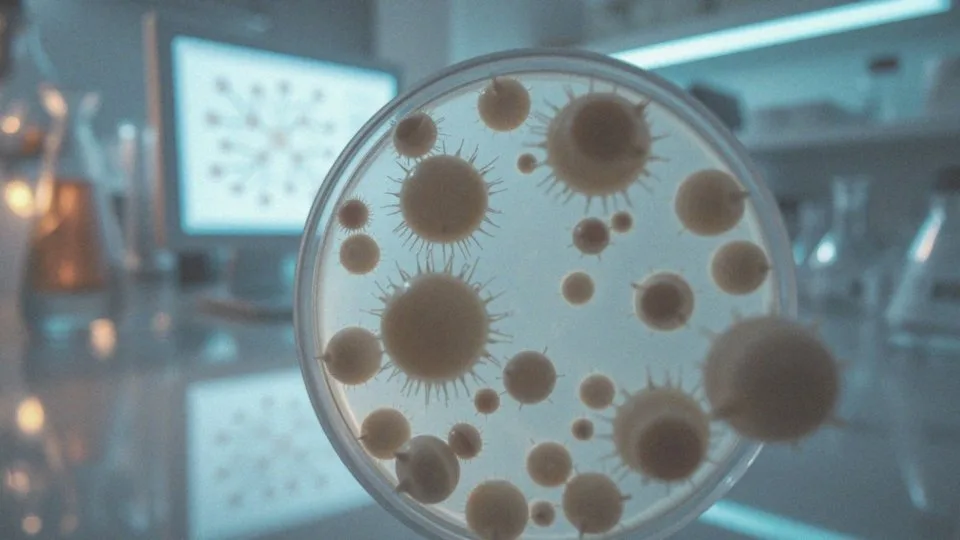
Jakie są etapy kancerogenezy?

Spis treści
Jak powstaje rak?
Rak powstaje w wyniku mutacji DNA, które transformują normalne komórki w nowotworowe. Ten złożony proces, znany jako kancerogeneza, jest wynikiem działania dwóch głównych grup czynników:
- czynniki zewnętrzne, do których zaliczają się promieniowanie, substancje chemiczne oraz wirusy onkogenne. Te elementy mają zdolność do uszkadzania DNA, co może prowadzić do poważnych konsekwencji zdrowotnych,
- czynniki wewnętrzne, dotyczące błędów, które powstają podczas replikacji DNA. Te naturalne uszkodzenia komórek mogą prowadzić do niekontrolowanego podziału, co sprzyja powstawaniu złośliwych nowotworów.
Przykładem czynników zewnętrznych są chemikalia zawarte w dymie papierosowym oraz różne zanieczyszczenia, które przyczyniają się do rozwoju raka płuc. Oprócz tego, genetyczne predyspozycje mogą zwiększać ryzyko wystąpienia nowotworów. Również styl życia, na przykład dieta oraz aktywność fizyczna, odgrywają kluczową rolę w naszym zdrowiu.
Nie można zapominać, że układ odpornościowy, który zazwyczaj pomaga w zwalczaniu komórek nowotworowych, może być osłabiony przez różnorodne czynniki, co sprzyja rozwojowi raka. Dlatego tak istotna jest świadomość ryzyka oraz regularne badania, które umożliwiają wczesne wykrywanie choroby. Wczesna diagnoza jest kluczowa dla poprawy rokowań pacjentów oraz zwiększenia ich szans na skuteczne leczenie.
Co to jest kancerogeneza?
Kancerogeneza to skomplikowany proces, w którym zdrowe komórki mogą przekształcać się w złośliwe nowotwory. Można go podzielić na trzy główne etapy:
- inicjację – kluczowy moment, gdy dochodzi do uszkodzenia DNA, co stanowi istotny krok w powstawaniu raka. Takie uszkodzenia mogą być wywołane przez różnorodne czynniki zewnętrzne, takie jak promieniowanie czy toksyczne substancje obecne w dymie papierosowym, które prowadzą do mutacji genetycznych,
- promocję – następują dalsze zmiany w strukturze genów. Komórki zaczynają intensywnie się namnażać, co skutkuje powstawaniem nieprawidłowych formacji. W tym okresie ich rozwój może być stymulowany przez różnorodne czynniki środowiskowe oraz hormonalne,
- progresję – końcowy etap tego procesu, który charakteryzuje się niekontrolowanym podziałem komórek nowotworowych. To prowadzi do inwazji na sąsiednie tkanki oraz do przerzutów, które mogą rozprzestrzeniać się do innych części ciała.
Całkowity proces kancerogenezy może trwać wiele lat, a jego zrozumienie jest kluczowe dla opracowania skutecznych strategii zapobiegawczych oraz terapeutycznych. Monitorowanie czynników ryzyka, takich jak uwarunkowania genetyczne, styl życia czy narażenie na substancje rakotwórcze, odgrywa kluczową rolę w zapobieganiu nowotworom.
Jakie są etapy kancerogenezy?
Kancerogeneza to złożony proces, który przebiega w trzech głównych etapach:
- inicjacja – dochodzi do uszkodzenia DNA komórki, co zasiewa ziarna mutacji. Czynniki wywołujące ten stan obejmują:
- promieniowanie UV,
- różnorodne substancje chemiczne.
- promocja – uszkodzone komórki zaczynają dzielić się w sposób niekontrolowany, co prowadzi do wzrostu liczby nieprawidłowych komórek. W tej fazie istotne są wpływy hormonalne oraz środowiskowe, które mogą sprzyjać dalszym zmianom genetycznym.
- progresja – nowotworowe komórki nabywają zdolność do inwazji sąsiednich tkanek oraz tworzenia przerzutów. W miarę rozwoju, złośliwe komórki uzyskują cechy pozwalające im na rozprzestrzenianie się w organizmie, co znacząco utrudnia skuteczne leczenie.
Dlatego właśnie zrozumienie tych etapów oraz czynników wpływających na rozwój nowotworów jest kluczowe dla ich wczesnej detekcji i prewencji.
Jakie są czynniki ryzyka powstawania nowotworów?
Czynniki ryzyka nowotworów można sklasyfikować w różne grupy. Przede wszystkim wyróżnia się czynniki genetyczne. Mutacje w genach supresorowych mogą znacznie zwiększać prawdopodobieństwo wystąpienia choroby. Osoby dotknięte dziedzicznymi zespołami, takimi jak zespół Lyncha czy zespół Bradwicha, są w wyższej grupie ryzyka rozwoju nowotworów.
Następnie mamy czynniki środowiskowe. Ekspozycja na promieniowanie jonizujące, na przykład podczas radioterapii lub w wyniku wypadków, może prowadzić do uszkodzenia DNA, co z kolei sprzyja powstawaniu nowotworów. Nie można zapomnieć o promieniowaniu ultrafioletowym ze słońca, które również zwiększa ryzyko raka skóry.
Styl życia odgrywa kluczową rolę w profilaktyce nowotworowej. Palenie papierosów to główny czynnik ryzyka raka płuc oraz innych zachorowań. Dodatkowo:
- nadużywanie alkoholu,
- niezdrowa dieta z dużą ilością przetworzonej żywności,
- brak ruchu
mogą przyczyniać się do rozwoju nowotworów. Infekcje wirusowe, w szczególności te onkogenne, jak wirusy HPV, HBV i HCV, są kolejnym ważnym czynnikiem ryzyka. Wirus brodawczaka ludzkiego (HPV) ma szczególne powiązania z rakiem szyjki macicy, a wirusy zapalenia wątroby mogą prowadzić do raka tego organu.
Czynniki zawodowe mogą podnosić to ryzyko. Narażenie na niebezpieczne substancje chemiczne, takie jak azbest czy benzen, stwarza poważne zagrożenie. Z tego powodu osoby pracujące w branży chemicznej lub budowlanej mogą być w kontakcie z rakotwórczymi substancjami.
Świadomość tych czynników ryzyka oraz ich unikanie mogą znacząco zmniejszyć prawdopodobieństwo wystąpienia nowotworów.
Co powoduje uszkodzenie genów?

Uszkodzenia genów mogą wynikać z różnych przyczyn, które wpływają na integralność DNA. Wśród głównych czynników znajdują się:
- promieniowanie jonizujące, takie jak promieniowanie X,
- promieniowanie ultrafioletowe,
- substancje chemiczne obecne w dymie tytoniowym, azbeście czy benzynie,
- wirusy onkogenne, takie jak HPV, HBV czy HCV.
Te mutacje mogą prowadzić do powstawania komórek nowotworowych, ponieważ uszkadzają mechanizmy naprawy DNA. Wirusy onkogenne mogą integrować swoje DNA z DNA gospodarza, co prowadzi do niekorzystnych zmian w komórkach. Oprócz tego, błędy, które pojawiają się podczas replikacji DNA, mogą skutkować powstawaniem zmutowanych komórek. Tego rodzaju nieprawidłowości mogą zakłócać prawidłowe funkcjonowanie organizmu, a zmutowane komórki, jeżeli nie są kontrolowane, potrafią się namnażać, co znacznie zwiększa ryzyko rozwoju nowotworów. Edukacja na temat tych zagrożeń jest niezwykle istotna. Proaktywne podejście do zdrowia, które uwzględnia te czynniki ryzyka, może znacząco przyczynić się do zmniejszenia szans na uszkodzenia genów oraz rozwój nowotworów.
Jak geny i mutacje wpływają na rozwój nowotworów?
Geny odgrywają kluczową rolę w procesie powstawania nowotworów, mając wpływ na wzrost, podział oraz apoptozę komórek. Gdy w tych genach zachodzą mutacje, mogą one prowadzić do tworzenia się niezdrowych komórek. Istnieją dwie główne kategorie genów, które mają znaczenie w tym kontekście:
- onkogeny – stymulują rozwój komórek,
- geny supresorowe – hamują rozwój komórek.
Kiedy dochodzi do zmian w genach supresorowych, często skutkuje to niekontrolowanym podziałem komórek. Mutacje te mogą być zarówno dziedziczne, jak i somatyczne. Te pierwsze mają szczególne znaczenie, ponieważ mogą być przekazywane z pokolenia na pokolenie. W rodzinach z historią nowotworów ryzyko ich pojawienia się może znacznie wzrosnąć, co można zidentyfikować poprzez specjalistyczne badania genetyczne.
Dlatego edukowanie ludzi na temat genów oraz potencjalnych mutacji jest niezwykle ważne. Zrozumienie wpływu tych mutacji na rozwój raka jest kluczowe dla postępu w badaniach nad nowymi metodami leczenia oraz wczesnego wykrywania nowotworów. Dodatkowo, podnoszenie świadomości społecznej i regularne kontrole zdrowotne przyczyniają się do obniżenia wskaźników zachorowalności na nowotwory.
Jakie chemiczne czynniki mogą prowadzić do nowotworów?
Chemiczne czynniki rakotwórcze, znane powszechnie jako kancerogeny, odgrywają kluczową rolę w rozwoju nowotworów. Ich działanie może prowadzić do uszkodzeń DNA, co z kolei wywołuje niepożądane mutacje. Wśród najistotniejszych zagrożeń chemicznych wyróżnia się:
- dym tytoniowy, który zawiera ponad 7000 szkodliwych substancji, w tym tak niebezpieczne jak benzo(a)piren i formaldehyd,
- azbest, który przyczynia się do rozwoju nowotworów płuc oraz międzybłoniaków,
- pestycydy, takie jak DDT, które mają udowodnione właściwości rakotwórcze,
- aflatoksyny, produkowane przez pleśnie, które występują w źle przechowywanych produktach rolnych, takich jak orzechy czy zboża,
- nadmierne spożycie alkoholu, które zwiększa ryzyko nowotworów, szczególnie w przypadku jamy ustnej, gardła, przełyku i wątroby.
Regularne picie powyżej 50 g etanolu dziennie drastycznie podnosi to ryzyko. Kancerogeneza to niezwykle złożony proces, w którym chemiczne czynniki ryzyka często współdziałają z innymi elementami, takimi jak genetyka i styl życia, co jeszcze bardziej potęguje prawdopodobieństwo wystąpienia nowotworów. Dlatego tak ważne jest, aby być świadomym tych zagrożeń, co jest kluczowe dla skutecznej profilaktyki i wczesnego wykrywania chorób nowotworowych.
Jakie role odgrywają czynniki fizyczne w karcinogenezie?
Czynniki fizyczne, takie jak promieniowanie jonizujące i ultrafioletowe (UV), odgrywają fundamentalną rolę w procesie powstawania nowotworów. Działają destrukcyjnie na DNA komórek, co z kolei prowadzi do występowania mutacji.
Promieniowanie jonizujące, w tym promieniowanie rentgenowskie i gamma, uszkadza DNA, co zwiększa ryzyko rozwoju nowotworów, a w szczególności białaczek. Z drugiej strony, promieniowanie UV jest głównym winowajcą raka skóry. Ekspozycja na takie promieniowanie prowadzi do zmian w komórkach, które mogą zaburzać ich naturalne procesy wzrostu. Osoby, które spędzają długie godziny na słońcu, zwłaszcza bez odpowiedniej ochrony, są bardziej podatne na ten rodzaj nowotworów.
Dlatego stosowanie filtrów przeciwsłonecznych oraz unikanie długotrwałej ekspozycji na słońcu to niezbędne kroki w zmniejszaniu ryzyka onkologicznego. Dodatkowo, kontrolowanie narażenia na promieniowanie w różnych kontekstach, zarówno medycznych, jak i zawodowych, jest kluczowe w prewencji nowotworów.
Zrozumienie wpływu tych czynników w mechanizmach karcinogenezy stanowi podstawę opracowywania efektywnych strategii zapobiegania oraz podnoszenia świadomości na temat zagrożeń związanych z promieniowaniem.
Co to są wirusy onkogenne i jak wpływają na powstawanie raka?
Wirusy onkogenne to specyficzne rodzaje wirusów, które mają zdolność wywoływania nowotworów. Dzieje się tak, gdy ich materiał genetyczny łączy się z DNA komórek gospodarza, co zaburza normalne procesy kontrolujące wzrost oraz podział komórek. Taki proces może prowadzić do przekształcenia tych komórek w komórki nowotworowe.
Wśród najbardziej rozpoznawalnych wirusów onkogennych możemy wymienić:
- wirus brodawczaka ludzkiego (HPV),
- wirus zapalenia wątroby typu B (HBV),
- wirus Epsteina-Barr (EBV).
Wirus HPV jest szczególnie na czołowej pozycji jako czynnik ryzyka w rozwoju raka szyjki macicy oraz innych nowotworów narządów płciowych. Z kolei HBV zwiększa prawdopodobieństwo wystąpienia raka wątroby, zwłaszcza u osób z przewlekłym zakażeniem. EBV natomiast jest powiązany z niektórymi rodzajami chłoniaków, co podkreśla jego potencjał onkogenny.
Sposób działania wirusów onkogennych opiera się na wprowadzaniu własnych genów do komórek gospodarza, co prowadzi do mutacji i nieprawidłowego funkcjonowania onkogenów oraz genów supresorowych. W tym kontekście zniekształcone szlaki sygnałowe odgrywają kluczową rolę, wpływając na cykl komórkowy. Na przykład niektóre wirusy mogą aktywować protoonkogeny, co skutkuje niekontrolowanym podziałem komórek.
Skutki zakażenia wirusami onkogennymi mogą mieć długotrwały charakter, dlatego wczesne wykrywanie i profilaktyka są niezwykle istotne w zmniejszaniu ryzyka rozwoju nowotworów. Szczepienia przeciwko HPV stanowią skuteczną strategię eliminacji ryzyka rozwoju raka szyjki macicy oraz pokazują, jak działania profilaktyczne mogą ograniczać obciążenie nowotworowe społeczności.
Zrozumienie roli wirusów onkogennych w powstawaniu nowotworów to kluczowy element w prewencji i edukacji zdrowotnej. Posiadanie takiej wiedzy przekłada się na efektywniejszą walkę z nowotworami oraz poprawia ogólny stan zdrowia społeczeństwa.
Jakie objawy mogą wskazywać na rozwój nowotworu?
Objawy nowotworów złośliwych mogą się różnić w zależności od ich rodzaju i lokalizacji w organizmie. Do najczęściej występujących symptomów zalicza się:
- niewytłumaczalną utratę masy ciała,
- nagłe uczucie zmęczenia, które nie mija nawet po odpoczynku,
- gorączkę bez wyraźnej przyczyny,
- trudności w oddychaniu lub połykaniu,
- przewlekły kaszel,
- zmiany w rytmie wypróżnień, takie jak biegunka lub zaparcia,
- krwawienia o nieznanym pochodzeniu,
- guzy lub obrzęki w różnych częściach ciała.
Te znaki powinny budzić niepokój. Regularne monitorowanie zmian skórnych, takich jak zmiany koloru, kształtu czy rozmiaru znamion, jest niezwykle ważne. Wczesne zidentyfikowanie nowotworu znacznie zwiększa szanse na skuteczne leczenie. Dlatego systematyczne badania profilaktyczne oraz uważna obserwacja wspomnianych objawów są kluczowe w profilaktyce nowotworowej.
Jakie są najczęstsze rodzaje nowotworów?
Nowotwory stanowią jedne z najczęstszych schorzeń, a ich występowanie różni się w zależności od płci, wieku, rasy oraz miejsca zamieszkania. Oto kilka rodzajów nowotworów:
- Rak płuc – uznawany za jeden z najgroźniejszych rodzajów nowotworów. Często wiąże się z paleniem papierosów i odpowiada za około 18% wszystkich zgonów związanych z rakiem.
- Rak piersi – najczęściej występujący typ nowotworu wśród kobiet. Każdego roku w Polsce dotyka około 20 000 kobiet. Wczesne wykrycie, za pomocą mammografii, znacząco zwiększa szanse na skuteczną terapię.
- Rak jelita grubego – czwarty najczęstszy nowotwór, który dotyka zarówno mężczyzn, jak i kobiety. Jego częstotliwość wzrasta wśród osób po pięćdziesiątce.
- Rak prostaty – najpowszechniejszy nowotwór u mężczyzn. Wczesne objawy mogą być trudne do zauważenia, dlatego regularne badania są istotne dla sprawnej diagnostyki.
- Rak skóry, w tym czerniak – ten rodzaj nowotworu często rozwija się w wyniku nadmiernego narażenia na promieniowanie UV. Czerniak jest uznawany za najgroźniejszą formę raka skóry.
- Rak żołądka – mimo że jego występowanie zmniejszyło się w ostatnich latach, wciąż stanowi znaczący problem zdrowotny w regionach z wysoką częstością tego nowotworu.
- Białaczka – to zespół nowotworów krwi, atakujący układ krwiotwórczy. Wyróżniamy tutaj różne typy, takie jak ostra i przewlekła.
Zrozumienie tych nowotworów oraz związanych z nimi ryzyk jest kluczowe dla ich wczesnego wykrywania i efektywnego leczenia. Regularne badania profilaktyczne są niezbędne, gdyż pozwalają na wczesne rozpoznawanie objawów i podejmowanie odpowiednich działań terapeutycznych.
Jakie są mechanizmy przerzutów w nowotworach?
Przerzuty stanowią niezwykle istotny etap w ewolucji nowotworów, a ich obecność niesie ze sobą poważne konsekwencje zdrowotne. Cały ten proces składa się z kilku kluczowych etapów:
- utrata adhezji międzykomórkowej, co umożliwia komórkom nowotworowym uwolnienie się od pierwotnego guza,
- inwazja błony podstawnej, co pozwala tym komórkom przemieścić się do sąsiednich tkanek,
- wejście do naczyń krwionośnych lub limfatycznych, co otwiera drogę do dalszych narządów,
- tworzenie nowych ognisk w nowych lokalizacjach, co zmniejsza szansę na skuteczne leczenie raka,
- angiogeneza, czyli proces powstawania nowych naczyń krwionośnych, dostarczających tlen i składniki odżywcze do rozwijających się guzów,
- unikanie odpowiedzi immunologicznej organizmu, co sprzyja przetrwaniu oraz rozwojowi komórek nowotworowych w nowych warunkach.
Zrozumienie tych mechanizmów jest niezwykle ważne, ponieważ stanowi fundament dla tworzenia skutecznych terapii, które mogą opóźnić ten proces oraz zwiększyć szanse na przeżycie pacjentów z nowotworami.
W jaki sposób profilaktyka może pomóc w wczesnym wykrywaniu nowotworów?

Profilaktyka odgrywa niezwykle istotną rolę w wczesnym wykrywaniu nowotworów, co w znacznym stopniu zwiększa możliwości skutecznego leczenia. Regularne badania, takie jak:
- mammografia,
- cytologia,
- kolonoskopowa,
- oznaczanie poziomu PSA,
są kluczowe dla zdrowia. Umożliwiają one identyfikację nowotworów na wczesnym etapie, co wpływa na lepsze efekty leczenia. Wczesne rozpoznanie nowotworów jest możliwe nie tylko dzięki systematycznym badaniom, ale także poprzez edukację społeczeństwa na temat symptomów i czynników ryzyka tych chorób. Osoby świadome zagrożeń, takich jak:
- palenie tytoniu,
- nadużywanie alkoholu,
- niezdrowa dieta,
chętniej podejmują kroki, by zredukować ryzyko zachorowania. Przykładem dobrych praktyk są szczepienia przeciw wirusom onkogennym, na przykład wirusowi brodawczaka ludzkiego (HPV), które skutecznie zmniejszają ryzyko wystąpienia niektórych rodzajów nowotworów, w tym raka szyjki macicy. Informowanie o tych wirusach jest kluczowym elementem profilaktyki nowotworowej. Dbanie o zdrowie oraz aktywne podejście do profilaktyki pozwalają na wczesne dostrzeganie zagrożeń i podejmowanie działań, które mogą uratować życie. Dzięki temu osoby z rozpoznanym nowotworem mają lepsze szanse na długoterminowe przeżycie i powrót do zdrowia.
Jakie zmiany w stylu życia mogą pomóc w prewencji nowotworów?
Zmiany w stylu życia mogą znacząco wpłynąć na zmniejszenie ryzyka wystąpienia nowotworów. Do najważniejszych czynników należy:
- unikanie palenia papierosów,
- nadmiernego spożycia alkoholu,
- właściwie zbilansowana dieta, obfitująca w owoce, warzywa oraz błonnik,
- utrzymywanie zdrowej masy ciała,
- systematyczna aktywność fizyczna,
- unikanie nadmiernej ekspozycji na promieniowanie ultrafioletowe,
- regularne badania zdrowotne.
Unikanie palenia oraz nadmiernego alkoholu są potwierdzonymi przyczynami wielu typów raka. Na przykład, warzywa krzyżowe, takie jak brokuły czy kapusta, zawierają substancje o działaniu przeciwnowotworowym. Utrzymywanie zdrowej masy ciała odgrywa kluczową rolę; otyłość może zwiększać ryzyko co najmniej 13 rodzajów nowotworów, w tym raka piersi oraz jelita grubego. Systematyczna aktywność fizyczna, rozumiana jako około 150 minut umiarkowanego wysiłku tygodniowo, może znacznie przyczynić się do obniżenia tego ryzyka. Ponadto, unikanie nadmiernej ekspozycji na promieniowanie ultrafioletowe oraz stosowanie filtrów przeciwsłonecznych stanowi istotny element w zapobieganiu rakowi skóry. Regularne badania zdrowotne, w tym szczepienia przeciw wirusom onkogennym, jak HPV i HBV, są kolejnymi ważnymi aspektami profilaktyki. Kształtowanie zdrowych nawyków już od najwcześniejszych lat to inwestycja w przyszłość zdrowia, która przyczynia się do redukcji ryzyka nowotworów. Edukacja na temat zdrowego stylu życia oraz konsekwentne podejście do profilaktyki są kluczowe w walce z tymi groźnymi chorobami.





